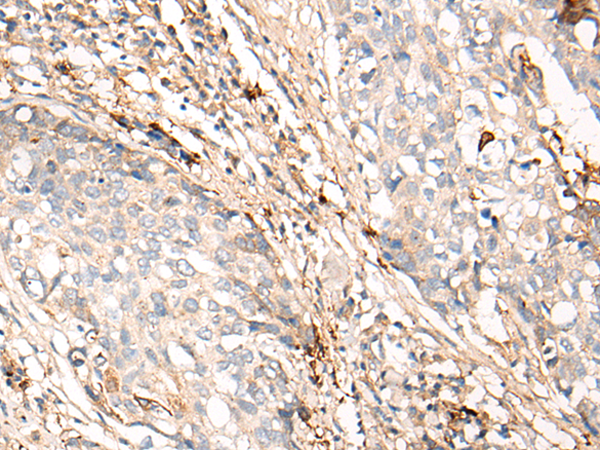

中文名稱:兔抗C4BPA多克隆抗體
|
Background: |
This gene encodes a member of a superfamily of proteins composed predominantly of tandemly arrayed short consensus repeats of approximately 60 amino acids. Along with a single, unique beta-chain, seven identical alpha-chains encoded by this gene assemble into the predominant isoform of C4b-binding protein, a multimeric protein that controls activation of the complement cascade through the classical pathway. The genes encoding both alpha and beta chains are located adjacent to each other on human chromosome 1 in the regulator of complement activation gene cluster. Two pseudogenes of this gene are also found in the cluster. |
|
Applications: |
ELISA, IHC |
|
Name of antibody: |
C4BPA |
|
Immunogen: |
Synthetic peptide of human C4BPA |
|
Full name: |
complement component 4 binding protein alpha |
|
Synonyms: |
PRP; C4BP |
|
SwissProt: |
P04003 |
|
ELISA Recommended dilution: |
5000-10000 |
|
IHC positive control: |
Human lung cancer and human ovarian cancer |
|
IHC Recommend dilution: |
10-50 |

購(gòu)物車
幫助
021-54845833/15800441009
